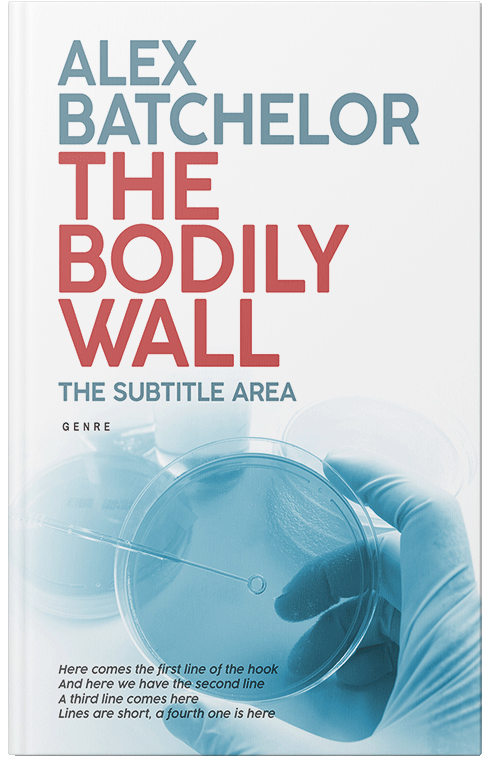
Front view of Premade Science & Nature Book Cover - Half Baked

Premade Science & Nature Book Cover - Half Baked
“A book cover featuring gloved hands holding a petri dish with bold red and blue text.”
Capture your readers' attention instantly with this exclusive Science & Nature book cover design. Perfect for self-publishing authors.
Key Features:
- 100% Human Created: No AI was used in the creation of this image.
- Exclusive Rights: Sold only once. The design is removed from our store upon purchase.
- Fully Customizable: Edit Title, Author, and Subtitle instantly.
What You Get:
- High-Resolution Ebook Cover: Ready for Amazon Kindle, Apple Books, and more.
- Print-Ready Option: Select "eBook Cover + Print" for a full PDF wrap (spine + back).
- Lifetime Updates: No time or revision limits on text changes.
The texts on this cover are just placeholders, added by the book cover designer. You can customize them instantly by clicking CUSTOMIZE.
This book cover has 3 lines for the title, 1 line for the subtitle, 2 lines for the author, 4 lines for the hook, and finally 1 line for the genre.
Tags: bacteria, analysis, biochemistry, biohazard, biotechnology, cells, copy space, culture, detection, development, differentiation, disease, education, equipment, experiment, food inspection, food poisoning, glassware, hygiene, identification, industrial, knowledge, lab, laboratory, laboratory instruments, measurement, media, medical, medicine, microbes, microbiology, new drug, pathogenic bacteria, petri dishes, pharmaceuticals, pharmacy, poisoning, pseudomonas aeruginosa, research, research positions, safety, settlements, test, test tubes, training, treatment, university, premade cover, book cover design, self-publishing, ebook cover, print ready
Purchase this book cover, starting from $99.00!
EBook Cover
- Professional EBook Cover Design
- High Resolution Files
- Multiple Format Support
- Commercial Rights Included
EBook Cover + Print
- Professional EBook Cover Design
- High Resolution Files
- Multiple Format Support
- Commercial Rights Included
- Print-Ready Cover Design
EBook Cover + Print + Title Page + Social Media Banners + Mockups
- Professional EBook Cover Design
- High Resolution Files
- Multiple Format Support
- Commercial Rights Included
- Print-Ready Cover Design
- Custom Title Page
- Social Media Banner Set
- Marketing Mockups
EBook Cover + Title Page + Social Media Banners + Mockups
- Professional EBook Cover Design
- High Resolution Files
- Multiple Format Support
- Commercial Rights Included
- Custom Title Page
- Social Media Banner Set
- Marketing Mockups
Can't find exactly what you're looking for?
We offer custom cover design services for your specific needs.
Order a Custom Book CoverMarket your book like a professional publishing house!
Once you've prepared your book and put it on sale in various marketplaces, you will need a comprehensive marketing strategy and most of it will be oriented around social media services. BookCoverZone offers professional marketing materials for Facebook, X, Instagram and LinkedIn for only $29! Just click on SOCIAL MEDIA MARKETING MATERIALS on the top of this page once you have prepared your cover and see your social media marketing materials immediately or purchase it directly by clicking on this button.
...and don't forget to publish a printed version of your book (for free!)
Amazon's self-publishing service Kindle Direct Publishing (KDP) as well as Ingram Spark are giving you the opportunity to publish your book for free in a printed format. Get the print package (front, spine and back) for an additional charge of $79.



















